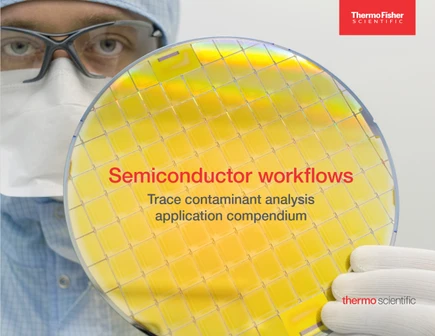
Přehled aplikací Thermo Scientific pro analýzy stopových kontaminantů při výrobě a zpracování polovodičů

Rozcestník
Další informace
WebinářeO násKontaktujte násPodmínky užití
LabRulez s.r.o. Všechna práva vyhrazena. Obsah dostupný pod licencí CC BY-SA 4.0 Uveďte původ-Zachovejte licenci.

Článek | Produkt
Stanovení PFAS a adsorbovatelného organického fluoru, chloru a bromu ve vodných matricích pomocí metody spalovací iontové chromatografie (C-IC)
Spalovací iontová chromatografie (C-IC) umožňuje citlivou analýzu PFAS a adsorbovatelných halogenů ve vodách, odpadech a půdách – nástroj pro ochranu životního prostředí a průmyslový dohled.
Út, 3.6.2025
Pragolab


Článek | Produkt
Představujeme: Revoluční platformu iontových chromatografů Thermo Scientific™ Dionex™ Inuvion™ z pohledu aplikací!
Systém Thermo Scientific Dionex Inuvion si můžete nakonfigurovat tak, aby vyhovoval konkrétním analytickým a finančním požadavkům, a podle potřeby jej snadno rekonfigurovat.
Út, 14.5.2024
Pragolab


Článek | Produkt
Přehled aplikací Thermo Scientific pro analýzy stopových kontaminantů při výrobě a zpracování polovodičů
Seznamte se s výrobou polovodičů a s tím, jak vám analytické přístroje Thermo Scientific mohou pomoci kontrolovat jednotlivé kroky procesu a analyzovat výrobní prostředí v průběhu celé výroby polovodičů.
Út, 23.1.2024
Pragolab
Další informace
WebinářeO násKontaktujte násPodmínky užití
LabRulez s.r.o. Všechna práva vyhrazena. Obsah dostupný pod licencí CC BY-SA 4.0 Uveďte původ-Zachovejte licenci.





